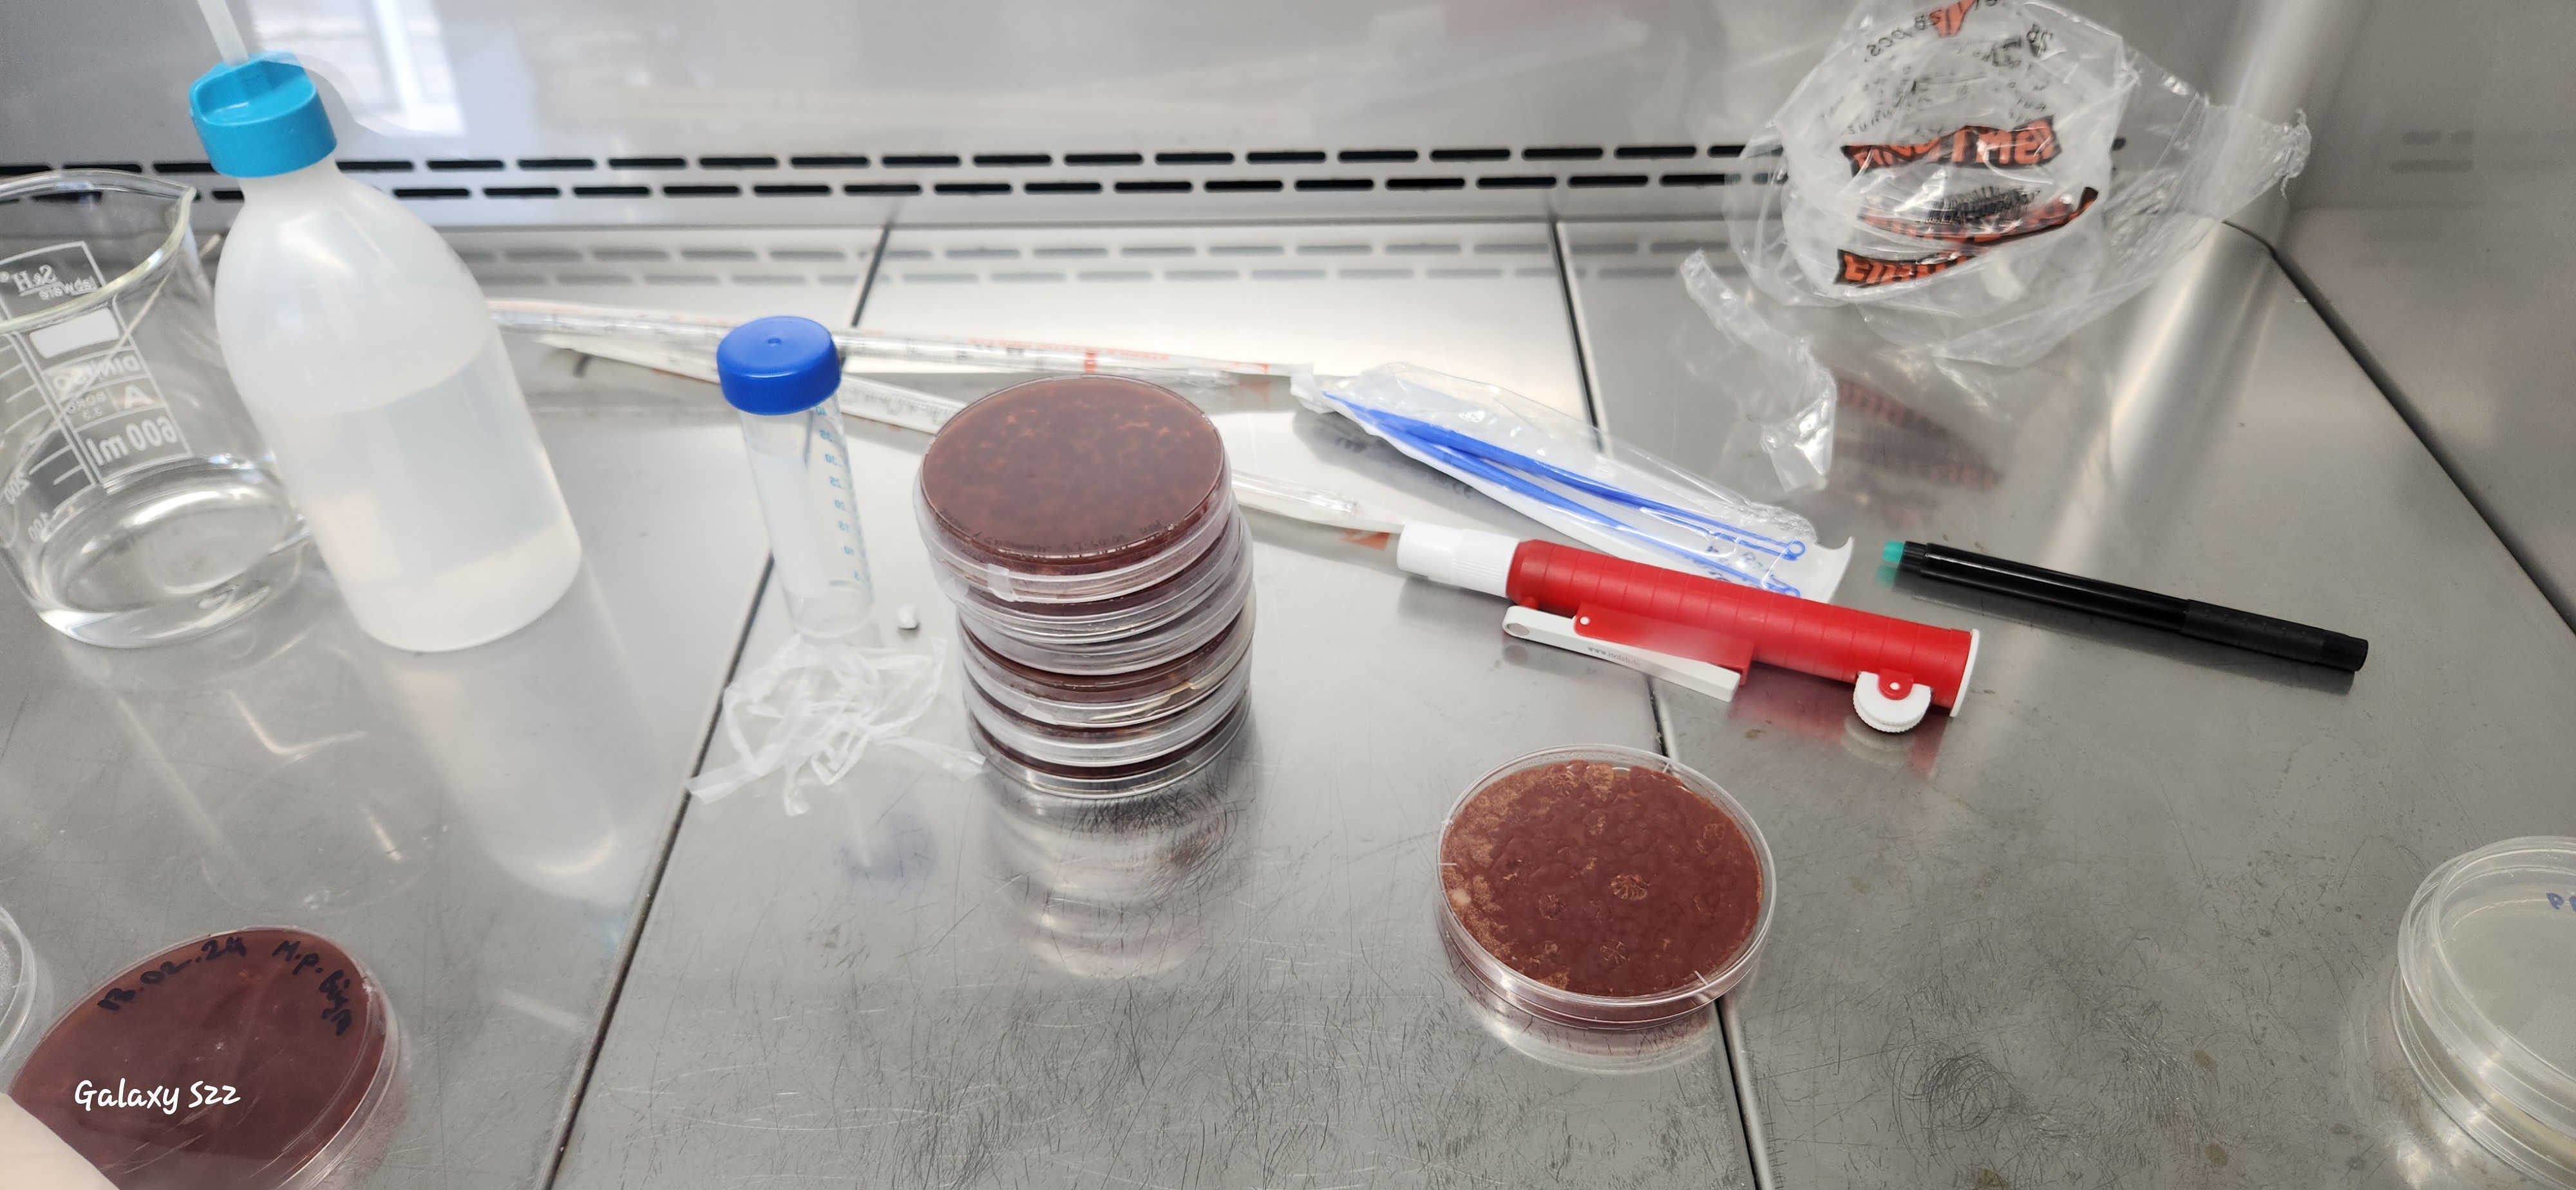
ARLAB5

We integrate the science of gastronomy, which enhances flavors, with the science of food science, which applies the fundamentals of fermentation, and scale it with engineering. We are pioneering innovation in gastroengineering.
Genc ve Naturel is an innovation startup founded by a mother, with an academic career in different disciplines from food science to gastronomy, and a white-collar father with a manager experience gained through all parts of food value chain. Here, we integrate our scientific potential with industrial experience to build synergy in designing advanced products. Like a master chef, in our laboratory, we put chemistry, microbiology, biotechnology, engineering and culinary arts to a pot and merge them smartly to enhance flavors, texture, health attributes and improve environmental footprints. As we reached a great recipe, we aim to scale it with advanced biotechnology applications and deliver them to our customers. Throughout the entire process, we continuously analyze our pilots by using appropriate objective and subjective analysis to validate all our efforts in the path of designing final product in the healthiest, sustainable as well as most delicious form.
Despite utilizing advanced and sophisticated technologies, we draw our inspiration from our cultural heritage. We take indigenous traditions, cultivated throughout human history and appealing to our sense of taste, and modernize them. The domestication of animals by our nomad ancestors contributed significantly to our civilization's rise to this level. But today things changed; livestock, which one add value to humanity by presenting almost its everything, even power, has now become a mere source of protein. Today's increasing consumption of animal protein poses a risk to our civilization. This makes us face to animal food paradox. We must find new alternative protein sources.
Genc ve Naturel chose to produce alternative proteins by processing plant biomass with selective microorganisms for making these sources edible and palatable, just as livestock produce protein and flavor for us. Our mission has evolved into combining alternative biomasses with suitable microorganisms and designing delicious and bioavailable products. This is precisely where we find microorganisms suitable for our children, isolate them, and manipulate them to create brand-new products and flavors. This is something like a new shepherding similar to our nomad ancestors did, but in a postmodern way. This micro-shepherding shall diversify our food sources, strengthen food security, and reduce inefficient resource consumption on our own. These new processes help us utilize idle biomass in creating new food materials while eliminating waste and side streams. We offer this wide range of services, in customizable modules, to individuals and organizations looking for this service.
We offer creative design applications, roadmaps, and service opportunities at every stage, from product organization to product launch, to individuals and organizations seeking advanced food and beverage product offerings. We can also distribute products derived from our own projects to various channels.

We offer scientific consulting, technical support, or stakeholder participation to individuals, institutions, and organizations that want to start scientific or commercial projects in the fields of food and beverages, and feed, from concept design to commercialization, including project writing, application, evaluation, project implementation, reporting, market acceptance and commercialization. We managed and accomplished project in national in international levels. If you are interested in participating in regional, national, and/or international projects in this field, you can benefit from our scientific expertise.
Get in touch
We are engaged in product development activities in the fields of innovative functional foods, beverages, and animal feed. Whether you are an investor seeking a successfully accomplished TUBİTAK project or an entrepreneur with a new idea, you can collaborate with us on product development. We can provide support at all technology readiness levels from TRL 1 to TRL 7 especially in novel and functional food and beverage development.
Get in touch
We offer a research kitchen, capable to handle various culinary operations for scientific research. We offer also a service and workshop area with a sufficient capacity; enables you make effective R&D throughout all stages from concept design and production to serving to last customer. We assist you conduct Living labs and Co-creation studies.
Get in touch
Whether you have a product idea, a prototype, or a product you're already producing, if you're looking to scientifically measure the appeal and acceptance of your products among your target customer base, we're happy to help. We utilize a full range of scientific techniques, from concept development and sensory panels to flavor profiling and market acceptance tests, to meet with your product's acceptance criteria. If you have an idea, we look forward to meeting you.
Get in touch
Whether it's a research action or an innovation action, or both together, whichever process you choose, we validate the process outputs during the design stages and verify them during the production stages. We have the infrastructure and experience to use both objective and subjective methods for this purpose. We can verify that you achieved your goals using many analysis techniques, such as analytical chemistry, rheology, chromatography, microbiological quality control, instrumental analysis, sensory evaluation, and flavor profiling.
Get in touchLet's discuss how we can help with your food research needs.
Contact Us